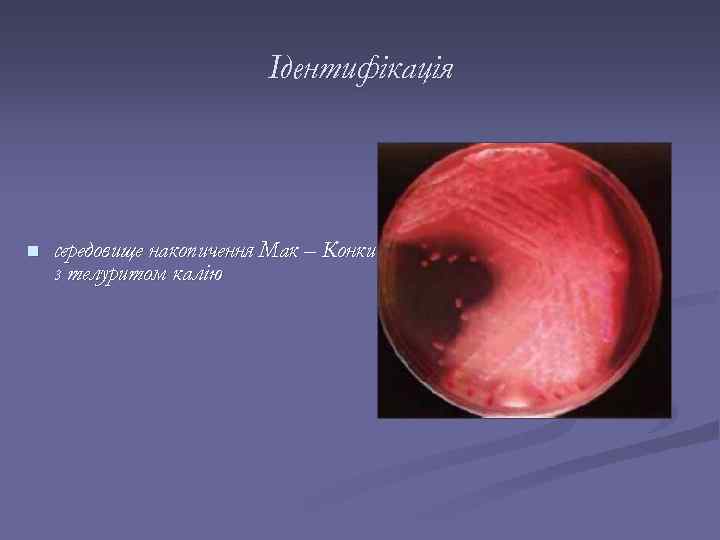
Ідентифікація n середовище накопичення Мак – Конки з телуритом калію

Enterococcus faecalis Санітарно – показовий мікроорганізм при санітарній оцінці води відкритих водойм
Enterococcus faecalis Санітарно – показовий мікроорганізм при санітарній оцінці води відкритих водойм
 Культурально – морфологічні ознаки n грампозитивні, попарно розташовані коки, трохи витягнуті в довжину, зовнішні кінці їх загострені
Культурально – морфологічні ознаки n грампозитивні, попарно розташовані коки, трохи витягнуті в довжину, зовнішні кінці їх загострені
 n ростуть на МПА, МПБ, але кращий ріст відзначений на середовищах, що містить вуглеводи й фактори росту, такі як дріжджовий екстракт діалізат
n ростуть на МПА, МПБ, але кращий ріст відзначений на середовищах, що містить вуглеводи й фактори росту, такі як дріжджовий екстракт діалізат
 Фізіолого – біохімічні ознаки n ферментує лактозу, маніт, гліцерин також ферментують, але не постійно сорбіт, арабінозу та сахарозу n витримує температуру 60 – 65 °С впродовж 30 хв, здатний рости в присутності 6, 5 % Na. Cl, 40 % жовчі, у середовищах із р. Н 9, 6 – 10
Фізіолого – біохімічні ознаки n ферментує лактозу, маніт, гліцерин також ферментують, але не постійно сорбіт, арабінозу та сахарозу n витримує температуру 60 – 65 °С впродовж 30 хв, здатний рости в присутності 6, 5 % Na. Cl, 40 % жовчі, у середовищах із р. Н 9, 6 – 10
 Санітарно – показове значення n n є постійним мешканцем кишечнику людини виявлення його у ґрунті, воді, харчових продуктах свідчить про фекальне забруднення цих об'єктів та продуктів
Санітарно – показове значення n n є постійним мешканцем кишечнику людини виявлення його у ґрунті, воді, харчових продуктах свідчить про фекальне забруднення цих об'єктів та продуктів
Ідентифікація n середовище накопичення Мак – Конки з телуритом калію
Ідентифікація n середовище накопичення Мак – Конки з телуритом калію
 Як збудник різних захворювань n фекальний ентерокок може бути збудником різних інфекцій: сечовивідних шляхів – бактеріурія, органів малого тазу, ранових, ендокардиту
Як збудник різних захворювань n фекальний ентерокок може бути збудником різних інфекцій: сечовивідних шляхів – бактеріурія, органів малого тазу, ранових, ендокардиту
 Застосування в харчовій промисловості n широко застосовується при виготовленні різних сортів сиру і молочних продуктів
Застосування в харчовій промисловості n широко застосовується при виготовленні різних сортів сиру і молочних продуктів
 Дякую за увагу!
Дякую за увагу!